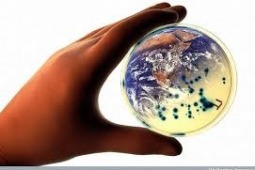

Piętnaście tysięcy reumatologów w San Diego
Tegoroczna konferencja ACR w San Diego zgromadziła piętnaście tysięcy ekspertów związanych z dziedziną reumatologii. Polska reprezentacja zamierza przedstawić relacje, konsensusy i wiedzę z kongresu na specjalnej konferencji w Poznaniu.
Tematy na konferencji były liczne i zróżnicowane, ale najostrzejsza debata dotyczyła leków biologicznych. Czy systemy opieki zdrowotnej poszczególnych państw stać na ich stosowanie? Jak na obniżenie kosztów wpłynie pojawienie się na rynku produktów biopodobnych?
Pytania można mnożyć, zauważa Nicola Garrett autorka „Rheumatology Update”. I dokłada własne: Czy powinniśmy używać potrójną terapię, aby pomóc obniżyć koszty ? Czy to zabieg równie skuteczny jak leczenie biologiczne?
Polska reprezentacja obecna na kongresie zda z niego sprawę już za niespełna dwa tygodnie, podczas konferencji POST EULAR & ACR 2013. -Zamierzamy przedstawić w miarę możliwości najważniejsze doniesienia z obydwu kongresów – organizowanego w Madrycie EULAR 2013 i w San Diego ACR 2013 – mówi prof. Włodzimierz Samborski, przewodniczący Komitetu Naukowego konferencji.
Konferencja odbędzie się w Poznaniu, w dniach 15 – 16 listopada.
Pytania można mnożyć, zauważa Nicola Garrett autorka „Rheumatology Update”. I dokłada własne: Czy powinniśmy używać potrójną terapię, aby pomóc obniżyć koszty ? Czy to zabieg równie skuteczny jak leczenie biologiczne?
Polska reprezentacja obecna na kongresie zda z niego sprawę już za niespełna dwa tygodnie, podczas konferencji POST EULAR & ACR 2013. -Zamierzamy przedstawić w miarę możliwości najważniejsze doniesienia z obydwu kongresów – organizowanego w Madrycie EULAR 2013 i w San Diego ACR 2013 – mówi prof. Włodzimierz Samborski, przewodniczący Komitetu Naukowego konferencji.
Konferencja odbędzie się w Poznaniu, w dniach 15 – 16 listopada.





